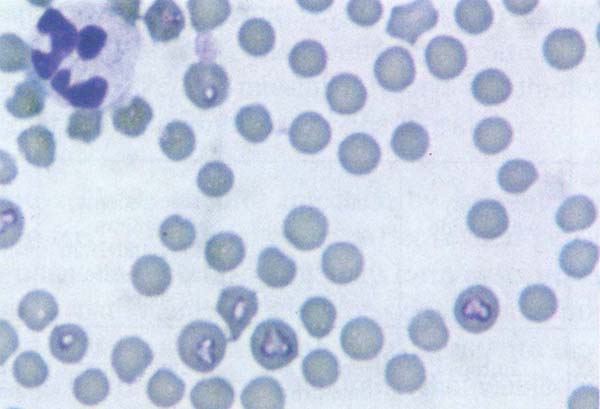

Dictyocaulus viviparus is a lung worm in cattle causing verminous pneumonia or bronchitis, husk or hoose. Mature lung worms live in the bronchi. During coughing the eggs are swallowed by the host. Hatching of eggs take place in air passages or the digestive tract. Larvae are passed in the faeces. These will survive and develop on the ground if moist and at moderate temperatures they will become invasive in 3 – 7 days. Larvae are resistant to the cold, although their maturation will be delayed.
Upon ingestion by the primary host larvae migrate through the intestinal wall to the mesenteric lymph nodes. From the mesenteric lymph nodes they pass via the lymphatics to the venous circulation and to the heart. From the heart they reach the lung alveoli. Three to six weeks after infection they migrate to bronchi where they mature and lay eggs. They survive 7 weeks in bronchi where they terminate their life cycle.
Antemortem findings :
Post mortem findings :
Judgement : Carcass of animal affected with lung worms is approved if infestation is slight and no secondary changes are observed. The lungs are condemned. The carcass is condemned if lung worm infestation has caused pneumonia which is accompanied with emaciation or anaemia.
Differential diagnosis : Bacterial bronchopneumonia, abscess, necrobacillosis, tuberculosis, actinobacillosis, hydatid disease and atelectasis
Fascioliasis is caused by different liver flukes. Fasciola hepatica is the most widespread in distribution. Fasciola gigantica in Africa and some parts of South East Asia and Fasciola magna found namely in North America including Canada and Europe. In Zimbabwe between 30–70 % of cattle slaughtered are infested with flukes. Usually the liver needs to be trimmed or condemned.
Fasciola hepatica (Fig. 86) is the most common of liver flukes. It is leaf shaped and measures 2.5 cm to 5 cm by 1.3 cm. It lives in the bile ducts of ruminants and other mammals.
Fasciola magna (Fig. 87) is one of the largest of flukes (10 cm by 2.5 cm) noted in the liver and rarely in the lungs of cattle, sheep, deer, moose, elk and other cervidae in Canada. It is found in North America. It may differentiated from Fasciola hepatica by the absence of an anterior cone like projection.
Fasciola gigantica is two or three times larger then Fasciola hepatica. It causes severe economic losses in cattle of Africa.

Fig. 86: Numerous flukes of Fasciola hepatica observed in the bile ducts and liver parenchyma of a cow.
3 The term “fascioliasis” is commonly used to cover all liver flukes”.

Fig. 87:Young fluke of Fascioloides magna taken from a bovine liver.
Life cycle : Each adult is hermaphroditic and produces fertilized eggs which are passed in the bile and faeces onto pasture. The eggs hatch, in the presence of water or moisture into larvae called miracidia. If the miracidia find a suitable intermediate host, which is usually the aquatic snail Limnea truncatula it will develop into sporocysts. In different parts of the world different snails act as intermediate hosts.
The sporocysts divide to form rediae. The rediae transform into cercariae which are the final larval stage of the cycle. They leave the snail and encyst into a metacercaria. After ingestion by a herbivorous animal, the cyst wall is digested in the duodenum and the larva crosses the small intestine wall and peritoneal space to the liver. It penetrates the liver and makes its way to the bile ducts and matures within a few weeks. The complete cycle of this fluke takes 3 –4 months in favourable conditions.
Antemortem findings :
Postmortem findings :

Fig. 88: Acute haemorrhagic tract in the bovine liver.
Judgement : Judgement depends on the extent of the fluke lesions and the condition of the carcass. Severe infestation with associated emaciation or edema would necessitate total condemnation of the carcass. Mild, moderate and heavy infestation without emaciation may have a favourable judgement. If the parasitic lesions in the liver are clearly circumscribed, the liver may be salvaged after trimming of affected tissue. Otherwise it is condemned.
Differential diagnosis : Melanosis, melanoma, Dicrocelium dendriticum and Gigantocotyle explanatum infections in South East Asia
Dicrocoelium dendriticum (the lancet fluke) is the smallest of the four mentioned flukes in the liver.
Life cycle : Two intermediate hosts are required for its complete cycle. The eggs excreted with faeces by the final host are ingested by a land snail. Many species of land snail can act as intermediate hosts where they develop into sporocysts and cercariae. Cionella lubrica is the principal first intermediate host in North America.
The cercariae are expelled by the snail in mucus and are deposited on plants. They are further ingested by ants of the genus Formica where they develop into metacercariae. Several species of this genus can act as second intermediate hosts. In North America Formica fusca is the second intermediate host.
Ruminants, while grazing, may ingest these ants. The cyst wall of the metacercariae is digested and larvae then migrate to the bile ducts where they mature. Dicrocoelium dendriticum is only slightly pathogenic and does not produce clinical symptoms in the animal.
Postmortem findings : In cattle, sheep and swine, the lancet fluke causes moderate thickening of the bile ducts, with slight damage to liver parenchyma. Upon close examination, the parasites can be seen in the bile ducts.
Judgement and differential diagnosis : see Fascioliasis
Oesophagostomiasis is a parasitic disease of ruminants and swine. Oesophagostomum radiatum is found in cattle, Oesophagostomum columbianum in sheep and Oesophagostomum dentatum in swine. The larvae in these species are found in the intestine, caecum and colon. In some Southern African the parasite may affect 5 – 10 % of cattle, sheep and pigs.
Life cycle : The larvae develop to the infective stage on pasture. They are sensitive to cold, dryness and temperature changes. The infected larvae penetrate the intestinal mucosa and many of them become encysted. The larvae which penetrate into deeper mucosal layers provoke an inflammatory reaction and nodules of “pimply gut”. Further stages of development occur in the intestinal wall. It is believed that many larvae are killed by the reaction they provoke in the intestine. When the larvae leave nodules due to malnutrition or lower resistance of the animal, they reach the colon. In the colon they become adults and attach themselves to the colonic mucosa where they lay eggs. A great number of nodules disappear as gross lesions after the departure of larvae. With repeated parasitic exposure, the host becomes immune and resistant to these larvae and local intestinal reaction becomes granulomatous. The nodules which surround dead larvae and those which calcify after caseation, are persistent and they protrude from the intestinal wall. This may explain why nodules are present in adult animals and why no adult worms are observed in the intestinal lumen. In young animals which have no immunity, adult worms are present in the lumen of the intestine and nodules are lacking. The are some adults with both, nodules and adult worms in the intestine. O. columbianum in sheep may cause extensive formation of nodules which may become suppurative and may rupture. This further lead to inflammation of the peritoneum and adhesions.
Antemortem findings :
Postmortem findings:
Judgement : Intestines affected with nodular worms are condemned. The carcass is also condemned, if severe infestation of this parasite is associated with emaciation and edema. Mild, moderate and heavy infestation without emaciation may have a favourable judgement. However, intestines should always be condemned as they cannot be used for sausage manufacture.

Fig. 89 : Oesophagostomiasis. Parasitic nodules on the intestinal mucosa (top) and serosa (bottom) in a young bovine animal.
Bovine cysticercosis is caused by Cysticercus bovis, which is the cystic form of the human tapeworm Taenia saginata.
Life cycle : Cysticercus bovis is the larval stage of Taenia saginata. Taenia saginata may grow from 3 – 7 m in length and lives in the intestine of man. It consists of a suckered head called scolex which is attached to the intestine. It also consist of a neck and hundreds of proglotid segments. Mature proglotids are filled with eggs. The proglotids break off and are excreted in the faeces where they fragment and release the ova. Cattle become infected by grazing on ground and by the digestion of foodstuff contaminated with human faeces. The oncosphere liberated in the intestine from the egg penetrates the intestinal wall and through the lymphatics and blood stream reaches the skeletal muscles and heart. In the muscles the oncosphere develops into the intermediate or cysticercus stage containing a scolex. The sites of predilection are the masseter muscles, tongue, heart and diaphragm. In some countries in Africa the cysticerci appear to show uniform distribution in the musculature. If ingested by man, the final or definite host, the scolex attaches itself to the intestinal wall and tapeworms then develop and mature (Fig. 90).
Transmission : Infection in man occurs following consumption of raw or undercooked beef containing viable cisticerci. Cattle become infected by ingestion of feedstuff containing ova passed from infected humans. Cattle raised on free range become often infected through contamination of grazing with human faeces. Infected farm workers may contaminate hay, silage, other feeds or sewage effluent. Intrauterine infection of a bovine fetus was also recorded.
Antemortem findings :
Heavy infestation in cattle may show:
Postmortem findings :
Fig. 90: Life Cycle of Taenia saginata (Courtesy of G. J. Jackson, Division of Microbiology, US FDA, Washington D. C., USA)

Judgement : Carcass and viscera of an infested animal should be differentiated with those with “heavy” infestation and those with “light” infestation. Carcass and viscera of heavily infested animals are condemned and those with light infestation should be treated either by boiling or freezing. The extent of “heavy infestation” is prescribed by the controlling authority. An animal is commonly considered heavily infected, if lesions are discovered in two of the usual inspection sites including the masseter muscles, tongue, oesophagus, heart, diaphragm or exposed musculature and in two sites during incisions into the shoulder and into the rounds. Generalized infection according to Canadian regulations means 2 or 3 cysts found on each cut into the muscles of mastication, heart, diaphragm and its pillars, and also if 2 or 3 cysts are found in muscles exposed during dressing procedures. In moderate or light infestation consisting of a small number of dead or degenerated cysticerci, the carcass is held depending on the existing country regulations for approximately 10 days at - 10° C.
Differential diagnosis: Hypoderma species (migration to heart), nerve sheath tumour, eosinophilic myositis, abscess and granuloma caused by injections

Fig. 91: Caseous cysticercus. Numerous clear transparent cysts on the heart surface. 0.6 mm in diameter in the heart muscle.
Hydatid disease in cattle is caused by the larval stages of the 2–7 mm long tape worm Echinococcus granulosus, which lives in the intestines of dogs and other carnivores. Several strains of E. granulosus exist, the cattle/dog strain is primarily responsible for hydatid disease in cattle. In Africa hydatid disease is reported more commonly in cattle that are communally owned or are raised on free range, and which associate more intimately with the domestic dogs. Hydatidosis in domestic ruminants inflicts enormous economic damage due to the condemnation of affected organs and lowering of the meat, milk and wool production.
Life cycle: The infective eggs containing the oncosphere passed in the faeces are accidentally ingested by cattle, sheep, pigs, other animals or humans which act as a intermediate hosts. After the infective eggs are ingested by these intermediate hosts, the oncospheres in the eggs penetrate the intestine and reach the liver, lungs and other organs including the brain and muscles to develop into hydatid cysts at the end of about five months. These cysts measure commonly 5 – 10 cm and contain fluid. Some may reach up to 50 cm in diameter. Others may produce daughters cysts. The diagnostic features of a hydatid cysts are a concentrically laminated thick outer layer within which is a germinal layer. In fertile hydatids the germinal layer is granular and has brood capsules each containing protoscoleces. When brood capsules become detached and float free in the cysts fluid they are referred to as hydatid sand. In some animals a fair proportion of hydatid may be sterile. The life cycle is completed when a fertile hydatid cyst is eaten by a definitive host, the dog or the appropriate carnivore. Cattle and majority of intermediate hosts show no clinical evidence of infection. However, in humans hydatid cysts can cause serious disease.
Antemortem findings: None of significance
Postmortem findings:
Hydatid cysts as described are found in :
Judgement: Carcass showing emaciation, edema and muscular involvement is condemned and destroyed. Otherwise the carcass is approved. Affected viscera and any other tissue are also condemned and destroyed. Burying of carcass is not sufficient, since dogs may retrieve the affected organs.
Differential diagnosis: Retention cysts in kidneys, cysts in liver, granulomatous lesions, Cysticercus tenuicolis and tuberculosis

Fig. 92: Hydatid cysts in bovine liver. (Courtesy Murdoch University, Perth, Australia)

Fig. 93: Hydatid cysts in bovine heart. Note the detached germinal layer.
Onchocercosis in cattle is caused nematodes of the genus Onchocerca. Several species are involved, but the most important species is Onchocerca gibsoni which causes sub-cutaneous nodules or “worm nests” in cattle in some countries of the Asia-Pacific region and Southern Africa.
Life cycle: The adult worm lives in the nodules and the fertilised females liberate microfilariae into the tissue lymph spaces from where they are taken up by an insect vector which act as an intermediate host. The common vectors are the midges of the genus Cullicoides. Other biting flies can act as intermediate hosts. The larvae develop to the infective stage in these insect vectors. Infection of cattle occurs when these biting flies with the infective larvae feed on them.
Antemortem findings : Careful palpation reveals sub-cutaneous nodules in the brisket and buttock regions.
Postmortem findings :
Judgement : The affected carcasses can be passed after the nodules have been removed. In heavy infestations the affected briskets are removed, and the tissue and the fascia around the stifle and the brisket are stripped off before the carcasses are passed.
Differential diagnosis : Abscesses, neurofibromatosis, cysticercosis, eosinophilic myositis

Fig. 94: Firm fibrous nodules of Onchocerca gibsoni in the brisket of an ox.
Parafilaria bovicola is a filarial parasite of cattle which causes focal cutaneous haemorrhage and sub-cutaneous lesions which are observed as bruising on a dressed carcass. The parasite occurs world wide in countries such as France, Canada, Sweden, South Africa and Zimbabwe, as well as other parts of Africa.
Transmission : The parasite is spread by several haematophagus species of the fly Musca.
Life cycle : During the 7 - 10 months life cycle of the worm, the fly picks up the egg off the skin surface of infected cattle. The larvae then develop in the fly, and are transmitted to the bovine through the saliva where they migrate subcutaneously and cause the lesions. The lesions appear like a bruise, hence the pseudonym “false bruising”. They have a greenish tinge due to the presence of a large number of eosinophils. The adult filaria pierces the skin and lays eggs around the periphery of the pierced hole.
Judgement : Lesions vary from mild and localized to severe and extensive. Mild and localized lesions require trimming of the affected portions and extensive lesions may warrant a total condemnation of the carcass.
This is a protozoan disease of animals and humans caused by parasites of the genus Trypanosoma, which are found in blood plasma, various body tissues and fluids.
Transmission : Trypanosoma are transmitted primarily by the Glossina spp., tsetse fly, Stomoxys, tabanid and reduviid bugs, and by venereal contact. Trypanosoma species in the insect vector undergo one or two cycles of development.
Antemortem findings :
Chronic form of trypanosomiasis is sometimes manifested by progressive weakness, despite absent parasitemia, and death.
Postmortem findings :
Judgement : The carcass affected with trypanosomiasis or any other protozoan diseases is condemned if an acute condition is associated with systemic body changes. Heat treatment may be recommended in some cases if economically feasible. The carcass of recovered and reactor animals may be approved if generalized lesions are lacking. Carcass showing borderline emaciation or slight edema should be examined after the 24 - 48 hours in the chiller. A satisfactory setting would lead to a favourable judgement of the carcass. The affected parts of the carcass and organs are condemned.
Differential diagnosis : Helminthiasis, malnutrition and other chronic wasting diseases, equine infectious anaemia, heartwater, babesiosis and anaplasmosis

Fig. 95: Trypanosomiasis. This animal shows icteric mucous membranes, weakness in leg muscles and emaciation.

Fig. 96: An impression smear of the trypanosomes and the RBC in the capillaries.

Fig. 97: Trypanosoma vivax in blood smear.
East coast fever is a subacute haemoprotozoan disease of cattle caused by Theileria parva. Theileriosis is characterized by fever, enlarged lymph nodes, dyspnea and death. In chronic cases loss of condition, emaciation, diarrhoea, blindness, etc. can be seen.
Transmission : Vectors are ixodid ticks of the species Rhipicephalus.
Antemortem findings :

Fig.98: East Coast fever (Theileriosis). Enlarged body lymph nodes.
Postmortem findings:
Confirmation of diagnosis is only made through detection of parasites in a Giemsa stained lymph node biopsy smear and/or blood smear.
Judgement: Carcass and viscera of an animal affected with febrile chronic theileriosis and without systemic lesions are approved. Carcass is condemned, if acute febrile theileriosis is accompanied with fever and generalized lesions. The affected organs are also condemned.
Differential diagnosis: Haemorrhagic septicemia, babesiosis, malignant catarrhal fever, trypanosomiasis, Rift Valley fever, heartwater and bovine leucosis

Fig.99: Theileriosis. Swollen edematous lungs and interstitial pneumonia.

Fig.100: Theileriosis. Infarcts, thrombosis and lymphoid hyperplasia in spleen.
Besnoitiosis is a chronic debilitating protozoan disease of cattle and horses. It also occurs in wild animals such as antelope, wildebeest (gnu) in Africa and caribou in Canada. The causative agent in cattle is Besnoitia besnoiti and Besnoitia benetti in horses.
The organism is closely related the genus Toxoplasma The mode of transmission is still unknown. It is believed that tabanids are mechanical vectors.
Antemortem findings :
Postmortem findings :
Judgement : The carcass is approved if the lesions are localized with no systemic involvement Carcass is condemned if disseminated, generalized lesions are accompanied with emaciation.
Differential diagnosis: Lumpy skin disease, sweating sickness and ectoparasitism (mites, ticks, fungi)

Fig. 101: Besnoitiosis. Sand like granules and cysts in the nostrils of an antelope.
Anaplasmosis is a rickettsial disease characterized by severe debility, emaciation, anaemia and jaundice and is caused by Anaplasma spp.. They are obligate intracellular parasites. Anaplasma marginale is the causative agent in cattle and wild ruminants.
Transmission: Boophilus species of ticks transmit anaplasmosis. Mosquitoes and the horsefly are mechanical transmitters. Transmission is also possible through injection needles.
Antemortem findings:
Acute infection with A. marginale
Postmortem findings :
Diagnosis can only be confirmed by detecting parasites in a blood smear stained with Giemsa.
Judgement : Carcass of an animal showing acute infection should be condemned. Recovered and “suspect” animals manifesting inconclusive signs of anaplasmosis are approved if otherwise healthy. A mildly yellow discoloured carcass may be chilled and assessed after setting. If the discoloration has disappeared, the carcass is approved. Animals affected with anaplasmosis could be treated under the supervision of a government official. Guidelines for the withdrawal period for therapeutic agents should be followed if the animals are being shipped for the slaughter.
Differential diagnosis : Icterus and anaemia of different causes, anthrax, leptospirosis, emaciation caused by parasitism and malignant lymphoma, babesiosis.
Remarks : The access of biting insects to contaminated fresh blood should be prevented. Blood from suspicious carcasses should not be salvaged.

Fig. 102: Anaplasmosis. Ox liver affected with disease showing distended bile ducts.
Babesiosis of cattle, horses, sheep and swine is a febrile, tick borne disease caused by various species of the protozoan genus Babesia.
Transmission : Different species of ticks in the family Ixodidae serve as vectors in different locations. The Babesia parasites can be transmitted transstadially and transovarially within a tick species.
Antemortem findings :
Postmortem findings :
Diagnosis can only be confirmed by identification of parasite in the peripheral blood smear stained with Giemsa (Fig. 104).
Judgement : Carcass of an animal in acute form of the disease, with associated icterus, is condemned. An emaciated, jaundiced carcass showing yellow gelatinous fat also requires total condemnation. A mild form of this disease showing yellow orange coloration of carcass not associated with icterus, may be approved. The satisfactory setting of the carcass in the chiller must be considered in this approval.
Differential diagnosis : Anaplasmosis, trypanosomiasis, theileriosis, leptospirosis and bacillary haemoglobinuria.

Fig. 103: Pink haemorrhage. Cerebral form of babesiosis caused by B. bovis. It is characterized by formation of thrombi and emboli in brain capillaries.
Fig. 104: Babesia bigemina in American bison blood.
Sarcocystosis is caused by the various species of the protozoan genus Sarcocystis. This is one of the most common parasitic conditions in domestic food animals and a high percentage of cattle in various parts of the world are infested with these parasites which are usually host specific. In cattle three species have been recognized. They are listed in Table 1. Cattle are the intermediate hosts of Sarcocystis spp. All Sarcocystis spp. in the intermediate hosts, the food animals, are characterised by the formation of cysts in the muscles.
| Species | Distribution | Definitive Host/s | Size of cyst | Pathogenicity |
|---|---|---|---|---|
| S. cruzi | World-wide | Dog, coyote, red fox, racoon and wolf | Microscopic, less than 0.5mm long. | Most pathogenic species in cattle it can cause fever, anaemia, abortion neurologic signs and even death. |
| S. hirsuta | Probably world-wide | Cat | Macroscopic, up to 8mm long and 1mm wide, fusiform in shape | Mildly pathogenic |
| S. hominis | Europe | Humans and some primates | Microscopic | Mildly pathogenic to cattle |
Life cycle: All Sarcocystis species require two hosts and a pre-predator cycle to complete their life-cycle. A herbivore, the prey, and a carnivore or omnivore, the predator are involved Sexual development occur in the predator which is therefore a definitive host, and asexual development occurs in the prey which is the intermediate host.
Two species, one in cattle (S. hominis) and one in pigs (S. suihominis) use humans as definitive hosts and therefore these infections in animals are zoonoses (Fig. 105). Generally speaking dog transmitted Sarcocystis are pathogenic and whereas cat transmitted ones are not.
The most important species in cattle is S. cruzi which has world-wide distribution and uses the dog as the definitive host. Sexual development takes place in the dog after which infective sporocysts are passed in the faeces. The details of development in cattle are illustrated in Fig. 106.
The buffalo is the intermediate host for two species: S. levinei which forms microscopic cysts and uses the dog as the definitive host, and S. fusiformis which forms macroscopic spindle or globular shaped cysts measuring 3.2cm × 8 mm and uses the cat as the definitive host. S. fusiformis cysts are seen in the oesophagus and the skeletal musculature and is common parasite of the waterbuffalo in many parts of the world.
Transmission : Cattle acquire infection by ingesting sporocysts contaminating feed, pasture or water. After several generations of asexual reproduction by schizogony they form cysts in muscles. S. cruzi, the most pathogenic species for cattle forms microscopic cysts. The definitive host, including humans acquire the infection when they eat bovine tissues containing the viable Sarcocystis cysts. The data provided below are for S. cruzi infestations, unless specified otherwise.
Fig. 105: Life cycle of Sarcocystis hominis (cattle) and Sarcocystis suihominis (pigs) in final host (man) (Courtesy G.J. Jackson, Division of Microbiology, US FDA, Washington D.C., USA)

Fig. 106: Life cycle of Sarococystis cruzi in the bovine and canine (prey-predator cycle)

Antemortem findings :
Postmortem findings :
Judgement: Judgement should be made on macroscopic presence of cysts. In heavy and widespread infestations with the visible cysts the whole carcass is condemned. In lighter infestations those parts of the carcass which are not affected are passed for human consumption. Microscopic examination of muscle may show as much as 70 % infestation in animals worldwide.
Differential diagnosis : Cysticercosis, toxoplasmosis, neurofibromatosis, eosinophilic myositis

Fig. 107: Sarcocystosis. Eosinophilic myositis.

Fig. 108: Histological section showing accumulation of eosinophiles and two microcysts of S. Cruzi. There is no tissue reaction.

Fig. 109: S. Fusiformis in the skeletal musculature of buffalo.
There are two warble flies in cattle, Hypoderma bovis and Hypoderma lineatum. They have similar cycles. During the summer the adult fly lays its eggs on the leg hair and occasionally on the body of cattle. Within a week the larvae hatch and burrow into the skin and, for several months they travel through the body. Hypoderma bovis migrates into the thoracic and abdominal cavities towards the spinal canal before moving under the skin of the back. Hypoderma lineatum migrates to the oesophageal area before reaching the dorsal area of the animal. In spring (February-May), the larvae reach the area of the back. They burrow a breathing hole and increase in size to approximately 8 mm × 25 mm. They are visible for a month. After this cycle, maggots fall to the ground where they develop into flies and start the whole cycle once again (Fig. 110).
Antemortem findings :
Postmortem findings :

Fig. 110: Hypoderma bovis. Life cycle of warble fly in cattle
Judgement : Carcass of an animal affected with Hypoderma bovis is approved. Subcutaneous lesions are removed.
Differential diagnosis : Cysticercus bovis cysts in oesophagus

Fig. 111: Hypoderma bovis. Larvae protruding from back in a 2 year old steer.

Fig. 112 Hypoderma bovis larvae.
Screwworm Myiasis caused by larvae of the flies Cochlliomyia hominironux (New World Screwworm - NWS) and Chrysomya bezziana (Old world screwworm - OWS), is characterized by larvae feeding on living tissues in open wounds of any warm blooded host including humans, resulting in weight loss, other signs of morbidity and sometimes death. The NWS is found in Central and South America including the Caribbean region. The OWS is located in India, Southeast Asia, Tropical Africa and in the Persian Gulf area.
Life Cycle : In the preferred temperature range (20 – 30°C) it is about 21 days. The female, which mates only once, lays one or more batches of up to 300 eggs at the edge of any wound or break in the skin in any warm blooded animal. Skin breaks as small as tick bites, as well as natural orifices can be sites of oviposition. The larvae develop within 24 hours, and burrow into the living flesh, creating large, deep, open wounds which attract further egg laying females. If unattended, these wounds are often fatal, particularly in newborn animals where the oviposition site is usually the navel.
Antemortem Findings : A serosanguinous discharge often exudes from the infested wounds, and a distinct odour may be detected. In some cases, the openings in the skin may be small with extensive pockets of screwworm larvae beneath. In dogs, screwworm larvae commonly tunnel under the skin. Screwworm infestations in anal, vaginal, and nasal orifices may be difficult to detect, even in the later stages.
Postmortem Findings : After 5 – 7 days of infestation, a wound may be expanded to 3 cm or more in diameter and 5 – 20 cm deep with larvae from a single screwworm egg mass. Usually by this stage, additional screwworm flies have deposited eggs, resulting in a multiple infestation. However, after the death the larvae leave the body due to the temperature reduction and some third stage instar larvae may pupate in the body.
Judgement : The affected carcasses can be passed after the wounds tissues have been removed and incinerated.
Differential diagnosis : Other blow flies as C. Macellaria and Sarcophagidae spp.

Fig. 112A: Wound of adult bovine infested by NWS.

Fig. 112B: Typical pocket like wound from screwworm larvae.

Fig. 112C: Screwworm. Life cycle